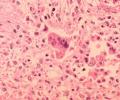

Ученые: привычка поздно ужинать в 3 раза повышает риск инсульта и диабета
Если наполнить желудок на ночь глядя, утром точно не будет аппетита. После позднего ужина люди, как правило, отказываются от завтрака, поскольку в организме еще ...
Российские десантники провели массовую высадку в Арктике
Впервые в истории России была проведена массовая высадка десантников в Арктике. Эта уникальная десантная операция прошла на аэродроме «Темп» полярного архипелага Новосибирских островов. Как ...
В Иркутской области сгорела подпольная нефтебаза
14.03.2014 09:32 / Происшествия / Комментариев (0)
Подпольная установка по переработке нефти в Ангарском районе Иркутской области загорелась в ночь на пятницу, 14 марта, сообщает пресс-служба регионального управления МЧС РФ. Подпольное ...
Ученые: чернослив укрепляет женские кости при остеопорозе
Специалисты из университета Флориды (США) доказали, что употребление чернослива укрепляет кости при возрастном остеопорозе у женщин. Исследователи изучали влияние чернослива на структуру костной ткани ...
Голливуд: Кристен Стюарт в 23 года начала стремительно стареть
14.03.2014 09:16 / Шоу-бизнес / Комментариев (0)
Звезду вампирской саги «Сумерки» Кристен Стюарт часто обвиняют в неряшестве, неаккуратности и игнорировании правил звездного стиля. В интервью американскому журналу «Elle» актриса объяснила, что ...
«Дом-2»: Павел Марсо не намерен жениться на беременной Рите Агибаловой
14.03.2014 09:16 / Шоу-бизнес / Комментариев (0)
Стало известно, что возлюбленный экс-участницы телестройки Маргариты Агибаловой, Павел Марсо, отказался узаконить сожительство с ней. Пара давно живет вместе и воспитывает сына Риты. Вскоре ...
В Башкирии «Газель» с пассажирами опрокинулась в кювет, 8 человек пострадали
14.03.2014 09:06 / Происшествия / Комментариев (0)
В Абзелиловском районе Башкирии опрокинулся пассажирский микроавтобус. Авария произошла днем в четверг на 14-м км автодороги Аскарово-Аэропорт, сообщили в пресс-службе республиканского ...
Алена Свиридова вместо масок и кремов рекомендует колоть ботокс
14.03.2014 08:56 / Шоу-бизнес / Комментариев (0)
51-летняя певица Алена Свиридова не боится говорить, сколько ей лет. Она уверена, что не выглядит на свои годы, хотя и не скрывает свой паспортный ...
Психологи: скрытность и подавление эмоций вредят мужскому сердцу
Психологи уверяют, что и мужчины, и женщины ощущают эмоции и переживания одинаково. Разницу формирует социум: укоренившиеся в сознании людей правила советуют дамам не скрывать ...